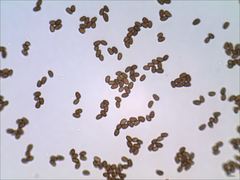
Psathyrella kauffmanii

Psathyrella kauffmanii: taxon details and analytics
- Domain
- Kingdom
- Fungi
- Phylum
- Basidiomycota
- Class
- Agaricomycetes
- Order
- Agaricales
- Family
- Psathyrellaceae
- Genus
- Psathyrella
- Species
- Psathyrella kauffmanii
- Scientific Name
- Psathyrella kauffmanii
Summary description from Wikipedia:
Images from inaturalist.org observations:
We recommend you sign up for this excellent, free service.
Parent Taxon
Sibling Taxa
- Agaricus comptulus
- Arenosae
- Atomatae
- Confusae
- Cystopsathyra
- Hydrophilae
- Jacobssoniorum
- Lutenses
- Microrhizae
- Noli-tangere
- Obtusatae
- Pennatae
- Psathyrella
- Psathyrella agrariella
- Psathyrella albescens
- Psathyrella almerensis
- Psathyrella angusticystis
- Psathyrella annulosa
- Psathyrella aquatica
- Psathyrella araguana
- Psathyrella arenulina
- Psathyrella argillospora
- Psathyrella artemisiae
- Psathyrella atrolaminata
- Psathyrella atrospora
- Psathyrella bambra
- Psathyrella barrowsii
- Psathyrella battarrae
- Psathyrella bifrons
- Psathyrella borealis
- Psathyrella campestris
- Psathyrella canadensis
- Psathyrella carinthiaca
- Psathyrella casca
- Psathyrella clivensis
- Psathyrella cloverae
- Psathyrella coloradensis
- Psathyrella conissans
- Psathyrella coprinoides
- Psathyrella coprophila
- Psathyrella cordobaensis
- Psathyrella corrugis
- Psathyrella crenulata
- Psathyrella debilis
- Psathyrella duchesnayensis
- Psathyrella dunensis
- Psathyrella ellenae
- Psathyrella elliptispora
- Psathyrella ephemera
- Psathyrella fagetophila
- Psathyrella fennoscandica
- Psathyrella frustulenta
- Psathyrella fulva
- Psathyrella fuscifolia
- Psathyrella glaucescens
- Psathyrella grisea
- Psathyrella griseola
- Psathyrella gruberi
- Psathyrella gyroflexa
- Psathyrella hispida
- Psathyrella hydrophora
- Psathyrella hymenocephala
- Psathyrella incerta
- Psathyrella involuta
- Psathyrella jalapensis
- Psathyrella janauariensis
- Psathyrella kauffmanii
- Psathyrella laevissima
- Psathyrella langei
- Psathyrella laurentiana
- Psathyrella lignatilis
- Psathyrella lionella
- Psathyrella longipes
- Psathyrella longistipes
- Psathyrella longistriata
- Psathyrella luteopallida
- Psathyrella madeodisca
- Psathyrella madida
- Psathyrella mesobromionis
- Psathyrella mexicana
- Psathyrella microcystis
- Psathyrella microsperma
- Psathyrella microsporoides
- Psathyrella murrillii
- Psathyrella narcotica
- Psathyrella niveobadia
- Psathyrella ocellata
- Psathyrella odorata
- Psathyrella ophirensis
- Psathyrella orbitarum
- Psathyrella oregonensis
- Psathyrella orizabensis
- Psathyrella palmigena
- Psathyrella paludosa
- Psathyrella pellucidipes
- Psathyrella praelonga
- Psathyrella praetenuis
- Psathyrella propinqua
- Psathyrella pseudogordonii
- Psathyrella pseudolarga
- Psathyrella pseudovernalis
- Psathyrella quercicola
- Psathyrella rogueiana
- Psathyrella rostellata
- Psathyrella roystoniae
- Psathyrella rubicola
- Psathyrella ruderaria
- Psathyrella rufogrisea
- Psathyrella rugocephala
- Psathyrella saccharinophila
- Psathyrella seminuda
- Psathyrella septentrionalis
- Psathyrella solheimii
- Psathyrella sphaerocystis
- Psathyrella spintrigera
- Psathyrella stuntzii
- Psathyrella suavissima
- Psathyrella subcaespitosa
- Psathyrella subhyalinispora
- Psathyrella sublateritia
- Psathyrella sublatispora
- Psathyrella subpannucioides
- Psathyrella subpurpurea
- Psathyrella subsingeri
- Psathyrella subtruncatispora
- Psathyrella sulcatotuberculosa
- Psathyrella thujina
- Psathyrella trepida
- Psathyrella truncatispora
- Psathyrella umbonata
- Psathyrella varicosa
- Psathyrella varzeae
- Psathyrella velibrunnescens
- Psathyrella vesiculocystis
- Psathyrella vinosofulva
- Psathyrella wapinitaensis
- Psathyrella wilsonensis
- Pseudostropharia
- Pygmaeae
- Saponaceae
- Sinefibularum
- Spadiceogriseae
- Stridvalliorum